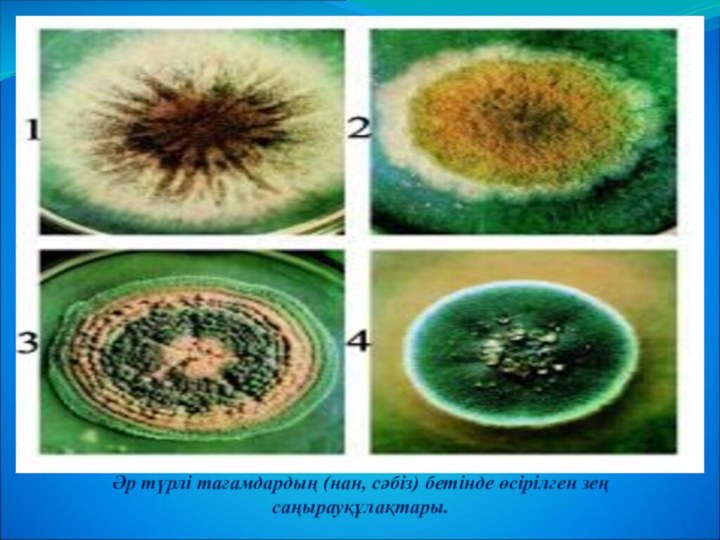

Ғылыми жоба
Жарық пен көлеңкенің микроорганизмдерге әсері

Орындаған: Шадырова Сауле Ергешбайкызы
2025 ж
Мазмұны
І. Кіріспе
Зерттеудің мақсаты
Міндеттері
Өзектілігі
Жаңашылдығы
ІІ. Негізгі бөлім
6.1. Микроорганизмдер дегеніміз не
6.2. Жарық пен көлеңкенің микроорганизмдерге әсері
6.3. Микроорганизмдердің тамаққа әсері (нан мен жеміс мысалында)
Практикалық бөлім
Тәжірибе жүргізу әдісі
Тәжірибелік нәтижелер
Нәтижелерді талдау
ІІІ. Қорытынды
Пайдаланған әдебиеттер
Кіріспе
Микроорганизмдер – өте кішкентай тіршілік иелері, оларды тек микроскоп арқылы ғана көруге болады. Олар біздің қоршаған ортада everywhere кездеседі: топырақта, суда, ауада, тіпті адамның және жануарлардың денесінде де бар. Кейбір микроорганизмдер пайдалы болып, адамдар мен жануарларға көмек көрсетсе, мысалы, сүт өнімдерін дайындауға қатысады, ал кейбіреулері зиянды, олар тамақты шірітіп немесе адамға ауру тудыруы мүмкін.
Мысалы, нан немесе жеміс уақыт өте келе көгеріп, шіріп кетеді. Бұл процеске микроорганизмдер тікелей әсер етеді: бактериялар мен саңырауқұлақтар нан мен жемістің бетінде өсіп, тамақты бүлдіреді. Сондықтан микроорганизмдердің тіршілігі мен олардың өсу жағдайын түсіну адам үшін маңызды.
Бұл ғылыми жобада мен жарық пен көлеңкенің микроорганизмдерге қалай әсер ететінін зерттеймін. Тәжірибені жасау үшін мен нан мен көгерген жеміс материалдарын қолданамын. Міз күн сәулесі түсетін және қараңғы жерде тұрған нан мен жемістің қалай өзгеретінін бақылап, микроорганизмдердің өсу жылдамдығын салыстырамын.
Жобаның нәтижесі арқылы мен:
микроорганизмдердің қандай жағдайда тез көбейетінін,
жарық пен көлеңкенің олардың тіршілігіне әсерін,
және күнделікті өмірде нан мен жемісті дұрыс сақтау жолдарын анықтай аламын.
Бұл зерттеу тек ғылыми білімді тереңдетіп қана қоймай, сонымен бірге балалардың тәжірибелік дағдыларын дамытып, табиғаттағы микроорганизмдердің рөлін түсінуге көмектеседі. Осы арқылы мен өз қоршаған ортаға сақ болуды, тамақты дұрыс сақтауды және тазалықты сақтаудың маңызын да айтамын.
Зерттеудің мақсаты
Ғылыми жобаның басты мақсаты – жарық пен көлеңкенің микроорганизмдердің көбеюіне қалай әсер ететінін бақылау, түсіну және талдау. Микроорганизмдер – өте кішкентай тіршілік иелері, олардың өсуін әртүрлі сыртқы факторлар басқарады. Сол факторлардың ішіндегі ең қарапайым әрі қолжетімдісі – жарық пен көлеңке.
Бұл жобаның мақсаты тек тәжірибелік бақылау жүргізу емес, сонымен қатар микроорганизмдердің табиғаттағы және күнделікті өмірдегі рөлін түсінуге мүмкіндік береді. Тәжірибе арқылы оқушы микроорганизмдердің:
жарыққа сезімтал екенін;
көлеңкелі және ылғалды ортада тез көбейетінін;
азық-түліктің сапасын төмендететінін көріп, ғылыми бақылау жасай алады.
Сонымен қатар, бұл зерттеудің мақсатына мыналар да кіреді:
-
Микроорганизмдердің өсіп-өну жағдайларын бақылау арқылы тәжірибелік дағдыларды дамыту.
-
Нан мен көгерген жеміс мысалында микроорганизмдердің әрекетін визуалды түрде көрсету.
-
Жарық пен көлеңкенің микроорганизмдердің тіршілігіне әсерін салыстырып, қорытынды жасау.
-
Оқушыларға азық-түлікті дұрыс сақтау маңызын түсіндіру және гигиена туралы білімді кеңейту.
Осылайша, жобаның мақсаты тек теориялық білімді тәжірибемен байланыстыруға ғана емес, сонымен қатар экологиялық мәдениетті қалыптастыруға, ғылыми ойлау қабілетін дамытуға, зерттеу әдістерін үйренуге бағытталған.
Міндеттері
Ғылыми жобаның міндеттері – мақсатқа жетуге бағытталған нақты қадамдар болып табылады. Бұл жобада міндеттер келесідей:
-
Микроорганизмдердің түрлері мен қасиеттерін зерттеу
Алғашқы қадам – микроорганизмдердің қандай түрлері бар екенін, олардың тіршілік ерекшеліктерін, өсу жағдайларын зерттеу. Мысалы, бактериялар мен саңырауқұлақтардың нан мен жемісте қалай өсетінін түсіну маңызды. Бұл бөлім оқушыға микроорганизмдердің әртүрлілігін, пайдалы және зиянды түрлерін ажырата білуге мүмкіндік береді. -
Жарық пен көлеңкенің микроорганизмдерге әсерін тәжірибе арқылы көрсету
Бұл міндет тәжірибелік бақылауды қамтиды. Біз жарық түсетін және қараңғы жерге қойылған нан мен жемістің қалай өзгеретінін күн сайын бақылаймыз. Тәжірибе арқылы оқушы микроорганизмдердің өсу жылдамдығына жарық пен көлеңкенің әсерін нақты көре алады. -
Нан мен жемістің микроорганизмдерге қалай ұшырайтынын бақылау
Бұл міндет нақты өмірлік жағдайға арналған. Нан мен жеміске микроорганизмдер әсер еткенде олардың бетінде қандай өзгерістер болатынын бақылау арқылы оқушы тамақтың шіріп немесе көгеру процесін түсінеді. Сонымен қатар, бұл міндет оқушыға азық-түлікті дұрыс сақтау қажеттілігін көрсетуге көмектеседі. -
Нәтижелерді салыстыру және қорытынды жасау
Тәжірибе аяқталғаннан кейін алынған деректерді талдау, жарықтағы және көлеңкедегі өзгерістерді салыстыру, қорытынды жасау – бұл міндет ғылыми жобаның ең маңызды бөлігі. Оқушы өз бақылауларына сүйене отырып, микроорганизмдердің тіршілігіне әсер ететін факторларды анықтап, тұжырым жасайды.
Осы міндеттерді орындау арқылы оқушы тек теориялық білімді ғана емес, практикалық дағдыларды да дамытады, ғылыми ойлау қабілетін қалыптастырады және табиғаттағы микроорганизмдердің рөлін терең түсінеді.
Өзектілігі
Тамақтың сақтау жағдайын дұрыс түсіну – адам денсаулығы үшін өте маңызды. Көптеген адамдар күнделікті нан мен жемісті дұрыс сақтамайды, нәтижесінде тамақ шіріп, көгеріп, микроорганизмдер көбейеді. Бұл тек азық-түліктің сапасын ғана емес, адам денсаулығын да қауіпке ұшыратады.
Бұл ғылыми жоба өзектілігін бірнеше себеппен дәлелдейді:
-
Денсаулық сақтау тұрғысынан
Микроорганизмдер кейде тамақты бүлдіретін ғана емес, ауру туғызуы мүмкін. Жобаның нәтижесі оқушыларға тамақты дұрыс сақтау және микроорганизмдердің зиянды әсерінен қорғану жолдарын көрсетуге мүмкіндік береді. -
Білім беру тұрғысынан
Жарық пен көлеңкенің микроорганизмдерге әсерін тәжірибе арқылы көрсету оқушыларға ғылыми ойлау қабілетін дамытып, бақылау мен салыстыру дағдыларын қалыптастырады. Бұл мектеп бағдарламасындағы табиғат пен биология тақырыптарына тікелей қатысты. -
Күнделікті өмірде қолдану мүмкіндігі
Жоба нәтижелері күнделікті тұрмыста маңызды: нан мен жемісті дұрыс сақтау, тамақты қауіпсіздік ережелеріне сай қолдану, азық-түлікті ұзақ сақтау жолдарын білу.
Сондықтан бұл зерттеу өзектілігі тұрғысынан маңызды, себебі ол микроорганизмдердің өмір сүру жағдайын, олардың өсуіне жарық пен көлеңкенің қалай әсер ететінін анықтап қана қоймай, оқушыға практикалық, өмірге тікелей қатысты білім береді.
Жаңашылдығы
Бұл ғылыми жоба жаңашылдығы мен ерекшелігі бойынша қарапайым, бірақ қызықты тәжірибе болып табылады. 4-сынып оқушысы үшін микроорганизмдерді зерттеу – жаңа тәжірибелік бағыт, себебі мектеп бағдарламасында көбіне тек теориялық білім беріледі, ал осы жобада оқушы өз қолымен тәжірибе жасап, нақты нәтижелерді бақылай алады.
Жобаның жаңашылдығы бірнеше аспектіден көрінеді:
-
Теорияны практикамен байланыстыру
Микроорганизмдер туралы алған теориялық білімді оқушы тәжірибе арқылы нақты өмірмен байланыстыра алады. Мысалы, жарық пен көлеңкедегі нан мен жемістің өзгерістерін бақылау – микроорганизмдердің тіршілігін көруге мүмкіндік береді. -
Қарапайым, бірақ әсерлі тәжірибе
Жобада қолданылатын әдістер қарапайым: нан, жеміс, жарық және көлеңке. Дегенмен, тәжірибенің нәтижелері қызықты, көрнекі және ғылымға қатысты маңызды қорытындылар береді. -
Оқушының өз ойы мен қорытындысын жасау мүмкіндігі
Тәжірибе барысында алынған деректерді салыстыру, талдау және қорытынды жасау – оқушыға ғылыми ойлау қабілетін дамытудың ерекше жолы. Бұл оның жеке зерттеуші ретінде білімін жетілдіруге септігін тигізеді. -
Күнделікті өмірмен байланысы
Жоба арқылы оқушы азық-түлікті дұрыс сақтау, микроорганизмдердің қауіпін түсіну, гигиена мен тазалыққа мән беру сияқты маңызды дағдыларды үйренеді.
Осылайша, бұл жоба жаңашылдығы мен қарапайымдылығын үйлестіре отырып, 4-сынып оқушысы үшін қызықты, тәжірибелік және ғылыми тұрғыдан маңызды зерттеу болып табылады.
ІІ. Негізгі бөлім
2.1. Микроорганизмдер дегеніміз не?
Микроорганизмдер – өте кішкентай тірі ағзалар, оларды адам көзімен көру мүмкін емес, тек микроскоп арқылы ғана байқауға болады. Бұл тіршілік иелері әртүрлі ортада өмір сүре алады: топырақта, суда, ауада, адамның және жануарлардың денесінде. Микроорганизмдер өте көп және әртүрлі болып келеді.
Олардың негізгі түрлері:
-
Бактериялар – ең көп таралған микроорганизмдер. Олар кейде пайдалы болып, кейде зиян келтіреді. Мысалы, бактериялар сүттің ашуын қамтамасыз етеді, бірақ кейбір бактериялар тамақты шірітеді немесе адамға ауру тудыруы мүмкін.

-
Саңырауқұлақтар – бұл микроорганизмдер көбіне ылғалды ортада жақсы өседі. Нан мен жеміс көгергенде саңырауқұлақтар белсенді түрде көбейеді. Олар тамақты бүлдіруімен қатар, табиғатта өлі өсімдіктерді ыдыратып, қоршаған ортаға пайдалы.

-
Вирустар – бактериялар мен саңырауқұлақтардан ерекшеленеді, себебі олар тірі жасушасыз өмір сүре алмайды. Вирустар тек тірі ағзаға енгенде ғана көбейеді.

Микроорганизмдер тіршілігін жалғастыру үшін жылу, ылғал, қоректік заттар сияқты қолайлы жағдай қажет етеді. Олар тез көбейе алады және тамаққа немесе қоршаған ортаға әсер ету арқылы әртүрлі процестерді туғызады.
Мысалы, нан уақыт өте келе көгеріп, жеміс шіріп кетеді. Бұл – микроорганизмдердің тіршілігі мен өсуінің көрінісі. Сондықтан оларды зерттеу өте маңызды, себебі микроорганизмдер тек зиян келтіріп қана қоймай, кейде пайдалы да болуы мүмкін.
Қорыта айтқанда, микроорганизмдер – кішкентай, бірақ өмірімізге үлкен әсері бар ағзалар. Оларды түсіну арқылы біз тамақты дұрыс сақтап, денсаулығымызды қорғауға үйренеміз.
2.2. Жарық пен көлеңкенің микроорганизмдерге әсері
Микроорганизмдердің өсуі олардың тіршілік ету ортасына байланысты өзгереді. Сол факторлардың ішінде жарық пен көлеңке ерекше рөл атқарады. Жарық пен көлеңкенің микроорганизмдерге әсерін түсіну үшін қарапайым мысалдармен түсіндіруге болады: нан мен жеміс уақыт өте келе көгеріп, шіріп кетеді. Бұл процесте жарық және көлеңке микроорганизмдердің өсу жылдамдығына тікелей әсер етеді.
Жарық
Көптеген Жарық олардың өсуін тежейді, себебі ультракүлгін сәуле кейбір микроорганизмдерді өлтіреді немесе олардың көбеюін баяулатады. Мысалы, нанды күн сәулесі түсетін терезе қасында қалдырсақ, оның беті баяу көгеріп, микроорганизмдер баяу өседі. Күн сәулесінің микроорганизмдерге әсері әр түрлі: кейбір бактериялар мен саңырауқұлақтар жарықта тіршілігін толық тоқтата алмайды, бірақ олардың көбею қарқыны айтарлықтай баяулайды.

Кейбір ерекше микроорганизмдер ультракүлгін сәулеге төзімді болып, жарықта да тіршілік ете алады. Дегенмен олардың саны әдетте аз болады, сондықтан жарық микроорганизмдердің көбейуін шектеуге көмектеседі. Бұл қасиет күнделікті өмірде тамақты сақтауда, мысалы, нанды терезе қасында немесе жарық түсетін сөрелерде қалдыру арқылы оның бұзылуын баяулата алады.
Көлеңке
Көлеңкелі және салқын жерлер микроорганизмдер үшін өте қолайлы орта болып табылады. Көлеңкеде ультракүлгін сәуле әсер етпейтіндіктен бактериялар мен саңырауқұлақтар тез көбейеді. Мысалы, нан немесе жемісті қараңғы орынға қойсақ, бетінде көгеру және саңырауқұлақтардың көбеюі жарықтағыдан айтарлықтай жылдам жүреді. Көлеңке микроорганизмдердің тіршілігіне қолайлы жағдай туғызып, олардың тез өсіп-өнуіне мүмкіндік береді.
Көлеңке микроорганизмдерге ылғал мен жылуды жақсы сақтайтын орта ұсынады. Сол себептен нан, жеміс немесе көкөністерді қараңғы және

салқын жерде сақтаған дұрыс, әйтпесе микроорганизмдер өте жылдам көбейіп, азық-түлікті бүлдіреді.
Практикалық маңыздылығы
Жарық пен көлеңкенің микроорганизмдерге әсерін білу арқылы біз тамақты дұрыс сақтауды үйренеміз. Мысалы:
нанды және жемісті салқын және жарық жерлерде сақтау;
көлеңкелі және ылғалды ортадан аулақ болу;
тамақ бұзылғанда оны уақытында алып тастау.
Сондай-ақ, бұл тәжірибе оқушыларға микроорганизмдердің тіршілігіне бақылау жасау, олардың өсу жылдамдығын салыстыру арқылы тәжірибелік дағды қалыптастыруға көмектеседі. Жарық пен көлеңкенің әсерін бақылау арқылы ғылымдағы бақылау мен салыстыру принциптерін түсінуге болады.
Қорыта айтқанда, жарық микроорганизмдердің өсуін баяулатады, ал көлеңке олардың көбейуіне қолайлы жағдай жасайды. Осы себептен тамақты сақтау кезінде жарық пен көлеңкенің рөлін ескеру қажет. Бұл бөлім тек теорияны ғана емес, практикалық өмірде қолдануға болатын маңызды кеңестерді де береді.
2.3. Микроорганизмдердің тамаққа әсері
Микроорганизмдер – бұл өте кішкентай тіршілік иелері, оларды адам көзімен көру мүмкін емес, бірақ олар тамаққа түскенде оның қасиетін өзгерте алады. Мысалы, нан немесе жеміс уақыт өте келе көгеріп, шіріп кетеді. Мұны көргенде адамға бұл тек тамақтың бұзылғанын ғана емес, сонымен бірге микроорганизмдердің белсенді тіршілігін де байқауға болады.
Микроорганизмдер тамаққа бірнеше жолмен әсер етеді:
-
Саңырауқұлақтардың әрекеті
Саңырауқұлақтар нан мен жемісте споралар арқылы көбейеді. Олар азық-түліктің бетінде ақ немесе жасыл түсті «көгеру» белгілерін қалдырады. Бұл көгеру процессі саңырауқұлақтардың қоректік заттарды пайдалануынан туындайды. Көгерген нан немесе жеміс адамға қауіп төндіруі мүмкін, сондықтан мұндай тамақты жеуге болмайды.

-
Бактериялардың әсері
Бактериялар тамақтың құрамындағы қоректік заттарды пайдалана отырып, тез көбейеді. Олардың көбеюі әсіресе жылы және ылғалды ортада жылдам жүреді. Мысалы, бөлме температурасындағы тәтті жеміс немесе жаңа піскен нан микроорганизмдер үшін өте қолайлы ортаны құрайды. Бактериялардың белсенділігі нәтижесінде тамақ иісі өзгереді, дәмі нашарлайды, кейде адамға ауру тудыруы мүмкін. -
Тамақтың сақтау жағдайының маңызы
Микроорганизмдердің тамаққа әсерін бақылау үшін сақтау жағдайын дұрыс ұйымдастыру өте маңызды.
Ылғалдылық: Тамақтағы су микроорганизмдердің тіршілік етуіне басты фактор болып табылады. Ылғалды тамақтарда микроорганизмдер тез көбейеді.
Температура: Жылы температура микроорганизмдердің өсуін тездетеді, ал салқын жерде тамақ баяу бұзылады.
Жарық пен көлеңке: Жарық микроорганизмдердің өсуін бәсеңдетеді, ал көлеңке олардың көбейуіне қолайлы орта жасайды.
-
Практикалық мысалдар
Егер нанды немесе жемісті күн сәулесі түсетін немесе салқын және құрғақ жерде сақтасақ, микроорганизмдердің өсуі баяулайды.
Ал егер оны жылы, ылғалды және көлеңкелі жерде қалдырсақ, саңырауқұлақтар мен бактериялар тез көбейіп, тамақ жылдам көгеріп, шіриді.

Бұл тәжірибе оқушыларға
микроорганизмдердің әрекетін нақты көрсетуге мүмкіндік береді. Олар
көрнекі түрде тамақтың қалай бұзылатынын, микроорганизмдердің
қандай жағдайларда белсенді болатынын байқай алады. Сонымен қатар,
бұл білім тамақты дұрыс сақтау, азық-түліктің қауіпсіздігін
қамтамасыз ету және денсаулықты қорғау үшін маңызды.
Микроорганизмдер – кішкентай, бірақ тамаққа үлкен әсер ететін
тіршілік иелері. Оларды бақылап, сақтау жағдайын дұрыс ұйымдастыру
арқылы біз азық-түлікті ұзақ мерзімде қауіпсіз сақтай
аламыз. Бұл
бөлім тек теориялық білімді көрсетіп қана қоймай, практикалық
өмірде қолдануға болатын маңызды дағдыларды
үйретеді.
Практикалық бөлім
1. Тәжірибе жүргізу әдісі
Бұл тәжірибе арқылы біз жарық пен көлеңкенің микроорганизмдердің өсуіне қалай әсер ететінін нақты көре аламыз.
Қажетті құралдар:
Ақ нан, алма немесе банан

Екі ыдыс немесе контейнер

Қараңғы орын және күн сәулесі түсетін орын

Сақтық қолғап және сүлгі

Фломастер немесе қағаз (тәжірибені жазу үшін)
Жүргізу тәртібі:
-
Нанды екі бөлікке бөліп, бірін күн сәулесі түсетін жерге, екіншісін қараңғы орынға қойыңыз.
-
Алманы немесе бананды да екіге бөліп, солай орналастырыңыз.
-
Күн сайын өзгерістерді бақылап, фотосурет немесе сурет арқылы жазып отырыңыз. Әр күнгі өзгерістерді кестеге түсірсеңіз, тәжірибе нәтижесін көрнекі етіп көрсетуге болады.
-
Тәжірибені 7 күн бойы жалғастырыңыз, күнделікті бақылау жасаңыз.
-
Жарықтағы және көлеңкедегі нандар мен жемістердің бетінде пайда болған өзгерістерді салыстырыңыз.
2. Тәжірибелік нәтижелер
|
Күн |
Жарықтағы нан/жеміс |
Көлеңкедегі нан/жеміс |
Ескертулер |
|
1 |
Өзгеріс жоқ |
Өзгеріс жоқ |
- |
|
2 |
Аздап құрғақтанды |
Көгеру басталды |
Көгеру белгілері көрінді |
|
3 |
Жеңіл өзгеріс |
Көгеру айқын |
Саңырауқұлақтар өсе бастады |
|
4 |
Жоғарғы қабаты ғана өзгерді |
Көгеру кеңінен таралды |
Иісі өзгере бастады |
|
5 |
Бетінде майда өзгеріс |
Толығымен көгерді |
Иісі күшті, саңырауқұлақтар көп |
|
6 |
Аздап көгеру |
Толығымен көгерген |
Тамақ шіріп барады |
|
7 |
Жеңіл өзгеріс |
Өте көгерген |
Тамақ қолдануға жарамсыз |
Көрнекі бақылау:
Күн сәулесі түсетін жерде нан мен жеміс баяу көгерді, көбінесе беті аздап өзгерді.
Көлеңкеде нан мен жеміс тез көгерді, бетінде саңырауқұлақтар мен көгеру белгілері көп пайда болды.
3. Нәтижелерді талдау
Тәжірибе көрсеткендей:
-
Көлеңкелі орта микроорганизмдердің белсенді көбеюіне өте қолайлы.
-
Жарық микроорганизмдердің өсуін бәсеңдетеді және нан мен жемістің көгеруін баяулатады.
-
Ылғал мен температура микроорганизмдердің көбею жылдамдығына әсер етеді: жылы және ылғалды ортада көгеру тез жүреді.
Қорытынды:
Тамақ сақтау кезінде жарық, көлеңке, температура және ылғалдылық факторларын ескеру керек.
Күн сәулесі түсетін немесе салқын жерлерде азық-түлікті сақтау микроорганизмдердің белсенділігін азайтып, тамақты ұзақ уақыт сақтау мүмкіндігін береді.
Бұл тәжірибе оқушыларға микроорганизмдердің әрекетін тәжірибелік түрде көрсетіп, теория мен практиканы байланыстыруға мүмкіндік береді.
Қорытынды
Бұл жобада біз жарық пен көлеңкенің микроорганизмдердің өсуіне қалай әсер ететінін зерттедік. Тәжірибе жасау барысында нан мен көгерген жеміс мысалында микроорганизмдердің тіршілігін бақыладық және олардың өсу жылдамдығын салыстырдық.
Нәтижелер көрсеткендей:
-
Жарық микроорганизмдердің өсуін бәсеңдетеді. Күн сәулесі түсетін жерде нан мен жеміс баяу көгерді, бетінде аздап ғана өзгерістер болды.
-
Көлеңке микроорганизмдердің тез көбеюіне қолайлы. Қараңғы жерде нан мен жеміс жылдам көгеріп, бетінде саңырауқұлақтар мен бактериялар көп пайда болды.
-
Ылғал мен температура да маңызды факторлар болып табылады. Жылы және ылғалды орта микроорганизмдердің өсуін жылдамдатады, ал құрғақ және салқын орта баяулатады.
Бұл тәжірибе оқушыларға микроорганизмдердің тіршілігін бақылауды, теориялық білімді практикамен байланыстыруды үйретеді. Сонымен қатар, тамақты дұрыс сақтау, азық-түліктің сапасын ұзақ сақтау және денсаулықты қорғау жолдарын түсінуге мүмкіндік береді.
Қорытындылай келе, жарық, көлеңке, температура және ылғал микроорганизмдердің өсуіне айқын әсер етеді. Бұл жобаның нәтижесі арқылы біз тамақ сақтау ережелерін дұрыс орындауды үйреніп, микроорганизмдердің тіршілігін бақылауда практикалық дағдыларды дамытуға мүмкіндік алдық.
Пайдаланған әдебиеттер
-
Петрова, Л. «Микроорганизмдер әлемі», Алматы, 2020.
-
Иванова, М. «Табиғаттағы микроорганизмдер», Астана, 2019.
-
Нұрбеков С., “Табиғаттағы тіршілік”, Алматы: Балдырған, 2019. – Жарық пен көлеңкенің тірі ағзаларға әсері.
-
Жартылыстану 4 сынып оқулығы, Алматы: Атамұра
-
Дүйсенбаев Б., “Балаларға арналған тәжірибелер”, Алматы: Білім, 2018. – Қарапайым тәжірибе жасау әдістері.
Ғылыми жобаның күнделігі
Тақырыбы: Жарық пен көлеңкенің
микроорганизмдерге әсері
Орындаған: Шадырова Сауле
Ергешбайкызы
1-күн:
Бүгін мен нан мен жемісті екі бөлікке бөлдім. Бірін күн сәулесі
түсетін жерге, екіншісін қараңғы орынға қойдым. Барлығы таза,
ешқандай өзгеріс байқалмады. Мен алғашқы бақылауды жасап,
фотосуретке түсірдім. Сонымен қатар, әр үлгіні бөлек белгілеп, қай
жерде тұрғанын жазып қойдым.
2-күн:
Көлеңкедегі нан мен жемісте алғашқы аздап көгеру байқалды, бетінде
жеңіл дақтар пайда болды. Жарықтағы үлгілер әлі өзгеріссіз қалды.
Мен күнделікті бақылау жүргізіп, өзгерістерді суретке түсірдім және
журналға жазып отырдым.
3-күн:
Көлеңкедегі үлгілерде көгеру кеңейіп, бетінде саңырауқұлақтар пайда
болды. Жарықтағы үлгілерде тек беткей өзгерістер байқалды. Бұл
микроорганизмдердің көлеңкеге тез бейімделетінін көрсетті. Мен әр
өзгерісті салыстырып жазып, тәжірибені
қадағаладым.
4-күн:
Көлеңкедегі үлгілердің түсі күңгірттеніп, бетінде көгеру айқын
көрінді. Жарықтағы үлгілерде тек жеңіл дақтар пайда болды. Мен
бақылауларымды суретке түсіріп, тәжірибе туралы жазбалар
жасадым.
5-күн:
Көлеңкедегі нан мен жеміс бетінде саңырауқұлақтар көп пайда болып,
иісі өзгере бастады. Жарықтағы үлгілерде тек үстіңгі қабатында
аздап өзгерістер болды. Бұл жарық микроорганизмдердің өсуін
бәсеңдететінін дәлелдеді. Мен әр үлгідегі өзгерістерді салыстырып
жаздым.
6-күн:
Көлеңкедегі үлгілер толық көгеріп, қолмен тигенде жұмсақ, иісі
өзгеше болды. Жарықтағы үлгілерде тек жеңіл беткей өзгерістер
байқалды. Мен әр күнде байқалған өзгерістерді суретке түсіріп,
журналға жазып отырдым.
7-күн:
Тәжірибе соңында көлеңкедегі үлгілер тамаққа жарамсыз болып шықты,
ал жарықтағы үлгілер салыстырмалы түрде жақсы күйде сақталды. Мен
барлық күндердегі өзгерістерді салыстырып, қорытынды жасадым.
Тәжірибе көрсеткендей, жарық микроорганизмдердің өсуін бәсеңдетеді,
ал көлеңке – олардың тез көбейуіне
қолайлы.
8-күн:
Көлеңкедегі үлгілердің бетінде көгеру толығымен таралып,
саңырауқұлақтар бетінің әр бөлігін жабып қалды. Иісі өте күшті және
нәзік қолмен тиіп көруге болмайтын күйде болды. Жарықтағы үлгілерде
тек үстіңгі қабатта жеңіл көгеру байқалды, бірақ иісі әлі қалыпты.
Мен күнделікті бақылауды жазып, фотосуретке түсірдім және
өзгерістерді салыстырдым.
9-күн:
Тәжірибе соңында көлеңкедегі нан мен жеміс толық бұзылғаны
анықталды, оларды адам үшін қолдануға болмайды. Жарықтағы үлгілер
салыстырмалы түрде жақсы күйде сақталды, бетінде тек жеңіл
өзгерістер байқалды, иісі қалыпты. Бұл күн тәжірибенің қорытынды
кезеңі болды: мен барлық күндердегі өзгерістерді салыстырып, жарық
пен көлеңкенің микроорганизмдердің өсуіне әсерін нақты
көрдім.
Аннотация
Бұл ғылыми жобада жарық пен көлеңкенің микроорганизмдердің өсуіне қалай әсер ететіні зерттелді. Жоба барысында мен нан мен көгерген жеміс мысалында микроорганизмдердің тіршілігін бақыладым. Тәжірибе көрсеткендей, жарыққа қойылған үлгілерде микроорганизмдер баяу көбейсе, көлеңкелі және салқын жерлерде олар тез көбейеді. Бұл тәжірибе микроорганизмдердің өсу жылдамдығына жарық пен температураның әсерін нақты көрсетті.
Теориялық бөлімде мен микроорганизмдердің түрлері, олардың қасиеттері, сондай-ақ тамаққа әсері туралы қарапайым және түсінікті ақпарат бердім. Практикалық бөлімде мен күнделікті бақылау жүргізіп, өзгерістерді суретке түсіріп, күнделікті жазбаларға тіркедім. Сонымен қатар, мен тәжірибе нәтижелерін салыстырып, қорытынды жасадым.
Бұл жоба оқушыларға микроорганизмдердің тіршілігін көрнекі түрде бақылауға, тәжірибелік дағдыларды дамытуға және тамақты дұрыс сақтау жолдарын үйренуге мүмкіндік береді. Жоба сонымен қатар логикалық ойлау қабілетін, салыстыру және қорытынды жасау дағдыларын жетілдіреді. Жобаның нәтижелері мектептік ғылыми жобалар конкурсына ұсынылуға және оқушылардың ғылымға деген қызығушылығын арттыруға лайық.
Аннотация
В этом научном проекте изучалось, как свет и тень влияют на рост микроорганизмов. В ходе исследования я наблюдал жизнь микроорганизмов на примере хлеба и заплесневелых фруктов. Эксперимент показал, что микроорганизмы растут медленно на свету, а в тени и в прохладных местах они размножаются быстрее. Это наглядно продемонстрировало влияние света и температуры на рост микроорганизмов.
В теоретической части проекта я представил информацию о видах микроорганизмов, их свойствах и влиянии на продукты питания. В практической части я ежедневно проводил наблюдения, фиксировал изменения с помощью фотографий и записей в дневнике. Также я сравнивал результаты эксперимента и делал выводы.
Проект позволяет учащимся наглядно наблюдать жизнь микроорганизмов, развивать практические навыки и учиться правильно хранить продукты. Он способствует развитию логического мышления, навыков сравнения и умения делать выводы. Результаты проекта подходят для участия в школьных научных конкурсах и повышают интерес детей к науке.
Abstract
This scientific project studies how light and shade affect the growth of microorganisms. During the research, I observed the life of microorganisms using bread and moldy fruit as examples. The experiment showed that microorganisms grow slowly in the light, while in shaded and cool places they multiply faster. This clearly demonstrated the effect of light and temperature on microorganism growth.
In the theoretical part of the project, I provided information about the types of microorganisms, their properties, and their effects on food. In the practical part, I conducted daily observations, recorded changes with photos, and kept a daily journal. I also compared the results of the experiment and made conclusions.
The project allows students to visually observe the life of microorganisms, develop practical skills, and learn how to store food properly. It helps to develop logical thinking, comparison skills, and the ability to make conclusions. The results of the project are suitable for school science competitions and help increase students’ interest in science.
жүктеу мүмкіндігіне ие боласыз
Бұл материал сайт қолданушысы жариялаған. Материалдың ішінде жазылған барлық ақпаратқа жауапкершілікті жариялаған қолданушы жауап береді. Ұстаз тілегі тек ақпаратты таратуға қолдау көрсетеді. Егер материал сіздің авторлық құқығыңызды бұзған болса немесе басқа да себептермен сайттан өшіру керек деп ойласаңыз осында жазыңыз
Жарық пен көлеңкенің микроорганизмдерге әсері
Жарық пен көлеңкенің микроорганизмдерге әсері
Ғылыми жоба
Жарық пен көлеңкенің микроорганизмдерге әсері

Орындаған: Шадырова Сауле Ергешбайкызы
2025 ж
Мазмұны
І. Кіріспе
Зерттеудің мақсаты
Міндеттері
Өзектілігі
Жаңашылдығы
ІІ. Негізгі бөлім
6.1. Микроорганизмдер дегеніміз не
6.2. Жарық пен көлеңкенің микроорганизмдерге әсері
6.3. Микроорганизмдердің тамаққа әсері (нан мен жеміс мысалында)
Практикалық бөлім
Тәжірибе жүргізу әдісі
Тәжірибелік нәтижелер
Нәтижелерді талдау
ІІІ. Қорытынды
Пайдаланған әдебиеттер
Кіріспе
Микроорганизмдер – өте кішкентай тіршілік иелері, оларды тек микроскоп арқылы ғана көруге болады. Олар біздің қоршаған ортада everywhere кездеседі: топырақта, суда, ауада, тіпті адамның және жануарлардың денесінде де бар. Кейбір микроорганизмдер пайдалы болып, адамдар мен жануарларға көмек көрсетсе, мысалы, сүт өнімдерін дайындауға қатысады, ал кейбіреулері зиянды, олар тамақты шірітіп немесе адамға ауру тудыруы мүмкін.
Мысалы, нан немесе жеміс уақыт өте келе көгеріп, шіріп кетеді. Бұл процеске микроорганизмдер тікелей әсер етеді: бактериялар мен саңырауқұлақтар нан мен жемістің бетінде өсіп, тамақты бүлдіреді. Сондықтан микроорганизмдердің тіршілігі мен олардың өсу жағдайын түсіну адам үшін маңызды.
Бұл ғылыми жобада мен жарық пен көлеңкенің микроорганизмдерге қалай әсер ететінін зерттеймін. Тәжірибені жасау үшін мен нан мен көгерген жеміс материалдарын қолданамын. Міз күн сәулесі түсетін және қараңғы жерде тұрған нан мен жемістің қалай өзгеретінін бақылап, микроорганизмдердің өсу жылдамдығын салыстырамын.
Жобаның нәтижесі арқылы мен:
микроорганизмдердің қандай жағдайда тез көбейетінін,
жарық пен көлеңкенің олардың тіршілігіне әсерін,
және күнделікті өмірде нан мен жемісті дұрыс сақтау жолдарын анықтай аламын.
Бұл зерттеу тек ғылыми білімді тереңдетіп қана қоймай, сонымен бірге балалардың тәжірибелік дағдыларын дамытып, табиғаттағы микроорганизмдердің рөлін түсінуге көмектеседі. Осы арқылы мен өз қоршаған ортаға сақ болуды, тамақты дұрыс сақтауды және тазалықты сақтаудың маңызын да айтамын.
Зерттеудің мақсаты
Ғылыми жобаның басты мақсаты – жарық пен көлеңкенің микроорганизмдердің көбеюіне қалай әсер ететінін бақылау, түсіну және талдау. Микроорганизмдер – өте кішкентай тіршілік иелері, олардың өсуін әртүрлі сыртқы факторлар басқарады. Сол факторлардың ішіндегі ең қарапайым әрі қолжетімдісі – жарық пен көлеңке.
Бұл жобаның мақсаты тек тәжірибелік бақылау жүргізу емес, сонымен қатар микроорганизмдердің табиғаттағы және күнделікті өмірдегі рөлін түсінуге мүмкіндік береді. Тәжірибе арқылы оқушы микроорганизмдердің:
жарыққа сезімтал екенін;
көлеңкелі және ылғалды ортада тез көбейетінін;
азық-түліктің сапасын төмендететінін көріп, ғылыми бақылау жасай алады.
Сонымен қатар, бұл зерттеудің мақсатына мыналар да кіреді:
-
Микроорганизмдердің өсіп-өну жағдайларын бақылау арқылы тәжірибелік дағдыларды дамыту.
-
Нан мен көгерген жеміс мысалында микроорганизмдердің әрекетін визуалды түрде көрсету.
-
Жарық пен көлеңкенің микроорганизмдердің тіршілігіне әсерін салыстырып, қорытынды жасау.
-
Оқушыларға азық-түлікті дұрыс сақтау маңызын түсіндіру және гигиена туралы білімді кеңейту.
Осылайша, жобаның мақсаты тек теориялық білімді тәжірибемен байланыстыруға ғана емес, сонымен қатар экологиялық мәдениетті қалыптастыруға, ғылыми ойлау қабілетін дамытуға, зерттеу әдістерін үйренуге бағытталған.
Міндеттері
Ғылыми жобаның міндеттері – мақсатқа жетуге бағытталған нақты қадамдар болып табылады. Бұл жобада міндеттер келесідей:
-
Микроорганизмдердің түрлері мен қасиеттерін зерттеу
Алғашқы қадам – микроорганизмдердің қандай түрлері бар екенін, олардың тіршілік ерекшеліктерін, өсу жағдайларын зерттеу. Мысалы, бактериялар мен саңырауқұлақтардың нан мен жемісте қалай өсетінін түсіну маңызды. Бұл бөлім оқушыға микроорганизмдердің әртүрлілігін, пайдалы және зиянды түрлерін ажырата білуге мүмкіндік береді. -
Жарық пен көлеңкенің микроорганизмдерге әсерін тәжірибе арқылы көрсету
Бұл міндет тәжірибелік бақылауды қамтиды. Біз жарық түсетін және қараңғы жерге қойылған нан мен жемістің қалай өзгеретінін күн сайын бақылаймыз. Тәжірибе арқылы оқушы микроорганизмдердің өсу жылдамдығына жарық пен көлеңкенің әсерін нақты көре алады. -
Нан мен жемістің микроорганизмдерге қалай ұшырайтынын бақылау
Бұл міндет нақты өмірлік жағдайға арналған. Нан мен жеміске микроорганизмдер әсер еткенде олардың бетінде қандай өзгерістер болатынын бақылау арқылы оқушы тамақтың шіріп немесе көгеру процесін түсінеді. Сонымен қатар, бұл міндет оқушыға азық-түлікті дұрыс сақтау қажеттілігін көрсетуге көмектеседі. -
Нәтижелерді салыстыру және қорытынды жасау
Тәжірибе аяқталғаннан кейін алынған деректерді талдау, жарықтағы және көлеңкедегі өзгерістерді салыстыру, қорытынды жасау – бұл міндет ғылыми жобаның ең маңызды бөлігі. Оқушы өз бақылауларына сүйене отырып, микроорганизмдердің тіршілігіне әсер ететін факторларды анықтап, тұжырым жасайды.
Осы міндеттерді орындау арқылы оқушы тек теориялық білімді ғана емес, практикалық дағдыларды да дамытады, ғылыми ойлау қабілетін қалыптастырады және табиғаттағы микроорганизмдердің рөлін терең түсінеді.
Өзектілігі
Тамақтың сақтау жағдайын дұрыс түсіну – адам денсаулығы үшін өте маңызды. Көптеген адамдар күнделікті нан мен жемісті дұрыс сақтамайды, нәтижесінде тамақ шіріп, көгеріп, микроорганизмдер көбейеді. Бұл тек азық-түліктің сапасын ғана емес, адам денсаулығын да қауіпке ұшыратады.
Бұл ғылыми жоба өзектілігін бірнеше себеппен дәлелдейді:
-
Денсаулық сақтау тұрғысынан
Микроорганизмдер кейде тамақты бүлдіретін ғана емес, ауру туғызуы мүмкін. Жобаның нәтижесі оқушыларға тамақты дұрыс сақтау және микроорганизмдердің зиянды әсерінен қорғану жолдарын көрсетуге мүмкіндік береді. -
Білім беру тұрғысынан
Жарық пен көлеңкенің микроорганизмдерге әсерін тәжірибе арқылы көрсету оқушыларға ғылыми ойлау қабілетін дамытып, бақылау мен салыстыру дағдыларын қалыптастырады. Бұл мектеп бағдарламасындағы табиғат пен биология тақырыптарына тікелей қатысты. -
Күнделікті өмірде қолдану мүмкіндігі
Жоба нәтижелері күнделікті тұрмыста маңызды: нан мен жемісті дұрыс сақтау, тамақты қауіпсіздік ережелеріне сай қолдану, азық-түлікті ұзақ сақтау жолдарын білу.
Сондықтан бұл зерттеу өзектілігі тұрғысынан маңызды, себебі ол микроорганизмдердің өмір сүру жағдайын, олардың өсуіне жарық пен көлеңкенің қалай әсер ететінін анықтап қана қоймай, оқушыға практикалық, өмірге тікелей қатысты білім береді.
Жаңашылдығы
Бұл ғылыми жоба жаңашылдығы мен ерекшелігі бойынша қарапайым, бірақ қызықты тәжірибе болып табылады. 4-сынып оқушысы үшін микроорганизмдерді зерттеу – жаңа тәжірибелік бағыт, себебі мектеп бағдарламасында көбіне тек теориялық білім беріледі, ал осы жобада оқушы өз қолымен тәжірибе жасап, нақты нәтижелерді бақылай алады.
Жобаның жаңашылдығы бірнеше аспектіден көрінеді:
-
Теорияны практикамен байланыстыру
Микроорганизмдер туралы алған теориялық білімді оқушы тәжірибе арқылы нақты өмірмен байланыстыра алады. Мысалы, жарық пен көлеңкедегі нан мен жемістің өзгерістерін бақылау – микроорганизмдердің тіршілігін көруге мүмкіндік береді. -
Қарапайым, бірақ әсерлі тәжірибе
Жобада қолданылатын әдістер қарапайым: нан, жеміс, жарық және көлеңке. Дегенмен, тәжірибенің нәтижелері қызықты, көрнекі және ғылымға қатысты маңызды қорытындылар береді. -
Оқушының өз ойы мен қорытындысын жасау мүмкіндігі
Тәжірибе барысында алынған деректерді салыстыру, талдау және қорытынды жасау – оқушыға ғылыми ойлау қабілетін дамытудың ерекше жолы. Бұл оның жеке зерттеуші ретінде білімін жетілдіруге септігін тигізеді. -
Күнделікті өмірмен байланысы
Жоба арқылы оқушы азық-түлікті дұрыс сақтау, микроорганизмдердің қауіпін түсіну, гигиена мен тазалыққа мән беру сияқты маңызды дағдыларды үйренеді.
Осылайша, бұл жоба жаңашылдығы мен қарапайымдылығын үйлестіре отырып, 4-сынып оқушысы үшін қызықты, тәжірибелік және ғылыми тұрғыдан маңызды зерттеу болып табылады.
ІІ. Негізгі бөлім
2.1. Микроорганизмдер дегеніміз не?
Микроорганизмдер – өте кішкентай тірі ағзалар, оларды адам көзімен көру мүмкін емес, тек микроскоп арқылы ғана байқауға болады. Бұл тіршілік иелері әртүрлі ортада өмір сүре алады: топырақта, суда, ауада, адамның және жануарлардың денесінде. Микроорганизмдер өте көп және әртүрлі болып келеді.
Олардың негізгі түрлері:
-
Бактериялар – ең көп таралған микроорганизмдер. Олар кейде пайдалы болып, кейде зиян келтіреді. Мысалы, бактериялар сүттің ашуын қамтамасыз етеді, бірақ кейбір бактериялар тамақты шірітеді немесе адамға ауру тудыруы мүмкін.

-
Саңырауқұлақтар – бұл микроорганизмдер көбіне ылғалды ортада жақсы өседі. Нан мен жеміс көгергенде саңырауқұлақтар белсенді түрде көбейеді. Олар тамақты бүлдіруімен қатар, табиғатта өлі өсімдіктерді ыдыратып, қоршаған ортаға пайдалы.
-
Вирустар – бактериялар мен саңырауқұлақтардан ерекшеленеді, себебі олар тірі жасушасыз өмір сүре алмайды. Вирустар тек тірі ағзаға енгенде ғана көбейеді.

Микроорганизмдер тіршілігін жалғастыру үшін жылу, ылғал, қоректік заттар сияқты қолайлы жағдай қажет етеді. Олар тез көбейе алады және тамаққа немесе қоршаған ортаға әсер ету арқылы әртүрлі процестерді туғызады.
Мысалы, нан уақыт өте келе көгеріп, жеміс шіріп кетеді. Бұл – микроорганизмдердің тіршілігі мен өсуінің көрінісі. Сондықтан оларды зерттеу өте маңызды, себебі микроорганизмдер тек зиян келтіріп қана қоймай, кейде пайдалы да болуы мүмкін.
Қорыта айтқанда, микроорганизмдер – кішкентай, бірақ өмірімізге үлкен әсері бар ағзалар. Оларды түсіну арқылы біз тамақты дұрыс сақтап, денсаулығымызды қорғауға үйренеміз.
2.2. Жарық пен көлеңкенің микроорганизмдерге әсері
Микроорганизмдердің өсуі олардың тіршілік ету ортасына байланысты өзгереді. Сол факторлардың ішінде жарық пен көлеңке ерекше рөл атқарады. Жарық пен көлеңкенің микроорганизмдерге әсерін түсіну үшін қарапайым мысалдармен түсіндіруге болады: нан мен жеміс уақыт өте келе көгеріп, шіріп кетеді. Бұл процесте жарық және көлеңке микроорганизмдердің өсу жылдамдығына тікелей әсер етеді.
Жарық
Көптеген Жарық олардың өсуін тежейді, себебі ультракүлгін сәуле кейбір микроорганизмдерді өлтіреді немесе олардың көбеюін баяулатады. Мысалы, нанды күн сәулесі түсетін терезе қасында қалдырсақ, оның беті баяу көгеріп, микроорганизмдер баяу өседі. Күн сәулесінің микроорганизмдерге әсері әр түрлі: кейбір бактериялар мен саңырауқұлақтар жарықта тіршілігін толық тоқтата алмайды, бірақ олардың көбею қарқыны айтарлықтай баяулайды.

Кейбір ерекше микроорганизмдер ультракүлгін сәулеге төзімді болып, жарықта да тіршілік ете алады. Дегенмен олардың саны әдетте аз болады, сондықтан жарық микроорганизмдердің көбейуін шектеуге көмектеседі. Бұл қасиет күнделікті өмірде тамақты сақтауда, мысалы, нанды терезе қасында немесе жарық түсетін сөрелерде қалдыру арқылы оның бұзылуын баяулата алады.
Көлеңке
Көлеңкелі және салқын жерлер микроорганизмдер үшін өте қолайлы орта болып табылады. Көлеңкеде ультракүлгін сәуле әсер етпейтіндіктен бактериялар мен саңырауқұлақтар тез көбейеді. Мысалы, нан немесе жемісті қараңғы орынға қойсақ, бетінде көгеру және саңырауқұлақтардың көбеюі жарықтағыдан айтарлықтай жылдам жүреді. Көлеңке микроорганизмдердің тіршілігіне қолайлы жағдай туғызып, олардың тез өсіп-өнуіне мүмкіндік береді.
Көлеңке микроорганизмдерге ылғал мен жылуды жақсы сақтайтын орта ұсынады. Сол себептен нан, жеміс немесе көкөністерді қараңғы және

салқын жерде сақтаған дұрыс, әйтпесе микроорганизмдер өте жылдам көбейіп, азық-түлікті бүлдіреді.
Практикалық маңыздылығы
Жарық пен көлеңкенің микроорганизмдерге әсерін білу арқылы біз тамақты дұрыс сақтауды үйренеміз. Мысалы:
нанды және жемісті салқын және жарық жерлерде сақтау;
көлеңкелі және ылғалды ортадан аулақ болу;
тамақ бұзылғанда оны уақытында алып тастау.
Сондай-ақ, бұл тәжірибе оқушыларға микроорганизмдердің тіршілігіне бақылау жасау, олардың өсу жылдамдығын салыстыру арқылы тәжірибелік дағды қалыптастыруға көмектеседі. Жарық пен көлеңкенің әсерін бақылау арқылы ғылымдағы бақылау мен салыстыру принциптерін түсінуге болады.
Қорыта айтқанда, жарық микроорганизмдердің өсуін баяулатады, ал көлеңке олардың көбейуіне қолайлы жағдай жасайды. Осы себептен тамақты сақтау кезінде жарық пен көлеңкенің рөлін ескеру қажет. Бұл бөлім тек теорияны ғана емес, практикалық өмірде қолдануға болатын маңызды кеңестерді де береді.
2.3. Микроорганизмдердің тамаққа әсері
Микроорганизмдер – бұл өте кішкентай тіршілік иелері, оларды адам көзімен көру мүмкін емес, бірақ олар тамаққа түскенде оның қасиетін өзгерте алады. Мысалы, нан немесе жеміс уақыт өте келе көгеріп, шіріп кетеді. Мұны көргенде адамға бұл тек тамақтың бұзылғанын ғана емес, сонымен бірге микроорганизмдердің белсенді тіршілігін де байқауға болады.
Микроорганизмдер тамаққа бірнеше жолмен әсер етеді:
-
Саңырауқұлақтардың әрекеті
Саңырауқұлақтар нан мен жемісте споралар арқылы көбейеді. Олар азық-түліктің бетінде ақ немесе жасыл түсті «көгеру» белгілерін қалдырады. Бұл көгеру процессі саңырауқұлақтардың қоректік заттарды пайдалануынан туындайды. Көгерген нан немесе жеміс адамға қауіп төндіруі мүмкін, сондықтан мұндай тамақты жеуге болмайды.

-
Бактериялардың әсері
Бактериялар тамақтың құрамындағы қоректік заттарды пайдалана отырып, тез көбейеді. Олардың көбеюі әсіресе жылы және ылғалды ортада жылдам жүреді. Мысалы, бөлме температурасындағы тәтті жеміс немесе жаңа піскен нан микроорганизмдер үшін өте қолайлы ортаны құрайды. Бактериялардың белсенділігі нәтижесінде тамақ иісі өзгереді, дәмі нашарлайды, кейде адамға ауру тудыруы мүмкін. -
Тамақтың сақтау жағдайының маңызы
Микроорганизмдердің тамаққа әсерін бақылау үшін сақтау жағдайын дұрыс ұйымдастыру өте маңызды.
Ылғалдылық: Тамақтағы су микроорганизмдердің тіршілік етуіне басты фактор болып табылады. Ылғалды тамақтарда микроорганизмдер тез көбейеді.
Температура: Жылы температура микроорганизмдердің өсуін тездетеді, ал салқын жерде тамақ баяу бұзылады.
Жарық пен көлеңке: Жарық микроорганизмдердің өсуін бәсеңдетеді, ал көлеңке олардың көбейуіне қолайлы орта жасайды.
-
Практикалық мысалдар
Егер нанды немесе жемісті күн сәулесі түсетін немесе салқын және құрғақ жерде сақтасақ, микроорганизмдердің өсуі баяулайды.
Ал егер оны жылы, ылғалды және көлеңкелі жерде қалдырсақ, саңырауқұлақтар мен бактериялар тез көбейіп, тамақ жылдам көгеріп, шіриді.

Бұл тәжірибе оқушыларға
микроорганизмдердің әрекетін нақты көрсетуге мүмкіндік береді. Олар
көрнекі түрде тамақтың қалай бұзылатынын, микроорганизмдердің
қандай жағдайларда белсенді болатынын байқай алады. Сонымен қатар,
бұл білім тамақты дұрыс сақтау, азық-түліктің қауіпсіздігін
қамтамасыз ету және денсаулықты қорғау үшін маңызды.
Микроорганизмдер – кішкентай, бірақ тамаққа үлкен әсер ететін
тіршілік иелері. Оларды бақылап, сақтау жағдайын дұрыс ұйымдастыру
арқылы біз азық-түлікті ұзақ мерзімде қауіпсіз сақтай
аламыз. Бұл
бөлім тек теориялық білімді көрсетіп қана қоймай, практикалық
өмірде қолдануға болатын маңызды дағдыларды
үйретеді.
Практикалық бөлім
1. Тәжірибе жүргізу әдісі
Бұл тәжірибе арқылы біз жарық пен көлеңкенің микроорганизмдердің өсуіне қалай әсер ететінін нақты көре аламыз.
Қажетті құралдар:
Ақ нан, алма немесе банан

Екі ыдыс немесе контейнер

Қараңғы орын және күн сәулесі түсетін орын

Сақтық қолғап және сүлгі

Фломастер немесе қағаз (тәжірибені жазу үшін)
Жүргізу тәртібі:
-
Нанды екі бөлікке бөліп, бірін күн сәулесі түсетін жерге, екіншісін қараңғы орынға қойыңыз.
-
Алманы немесе бананды да екіге бөліп, солай орналастырыңыз.
-
Күн сайын өзгерістерді бақылап, фотосурет немесе сурет арқылы жазып отырыңыз. Әр күнгі өзгерістерді кестеге түсірсеңіз, тәжірибе нәтижесін көрнекі етіп көрсетуге болады.
-
Тәжірибені 7 күн бойы жалғастырыңыз, күнделікті бақылау жасаңыз.
-
Жарықтағы және көлеңкедегі нандар мен жемістердің бетінде пайда болған өзгерістерді салыстырыңыз.
2. Тәжірибелік нәтижелер
|
Күн |
Жарықтағы нан/жеміс |
Көлеңкедегі нан/жеміс |
Ескертулер |
|
1 |
Өзгеріс жоқ |
Өзгеріс жоқ |
- |
|
2 |
Аздап құрғақтанды |
Көгеру басталды |
Көгеру белгілері көрінді |
|
3 |
Жеңіл өзгеріс |
Көгеру айқын |
Саңырауқұлақтар өсе бастады |
|
4 |
Жоғарғы қабаты ғана өзгерді |
Көгеру кеңінен таралды |
Иісі өзгере бастады |
|
5 |
Бетінде майда өзгеріс |
Толығымен көгерді |
Иісі күшті, саңырауқұлақтар көп |
|
6 |
Аздап көгеру |
Толығымен көгерген |
Тамақ шіріп барады |
|
7 |
Жеңіл өзгеріс |
Өте көгерген |
Тамақ қолдануға жарамсыз |
Көрнекі бақылау:
Күн сәулесі түсетін жерде нан мен жеміс баяу көгерді, көбінесе беті аздап өзгерді.
Көлеңкеде нан мен жеміс тез көгерді, бетінде саңырауқұлақтар мен көгеру белгілері көп пайда болды.
3. Нәтижелерді талдау
Тәжірибе көрсеткендей:
-
Көлеңкелі орта микроорганизмдердің белсенді көбеюіне өте қолайлы.
-
Жарық микроорганизмдердің өсуін бәсеңдетеді және нан мен жемістің көгеруін баяулатады.
-
Ылғал мен температура микроорганизмдердің көбею жылдамдығына әсер етеді: жылы және ылғалды ортада көгеру тез жүреді.
Қорытынды:
Тамақ сақтау кезінде жарық, көлеңке, температура және ылғалдылық факторларын ескеру керек.
Күн сәулесі түсетін немесе салқын жерлерде азық-түлікті сақтау микроорганизмдердің белсенділігін азайтып, тамақты ұзақ уақыт сақтау мүмкіндігін береді.
Бұл тәжірибе оқушыларға микроорганизмдердің әрекетін тәжірибелік түрде көрсетіп, теория мен практиканы байланыстыруға мүмкіндік береді.
Қорытынды
Бұл жобада біз жарық пен көлеңкенің микроорганизмдердің өсуіне қалай әсер ететінін зерттедік. Тәжірибе жасау барысында нан мен көгерген жеміс мысалында микроорганизмдердің тіршілігін бақыладық және олардың өсу жылдамдығын салыстырдық.
Нәтижелер көрсеткендей:
-
Жарық микроорганизмдердің өсуін бәсеңдетеді. Күн сәулесі түсетін жерде нан мен жеміс баяу көгерді, бетінде аздап ғана өзгерістер болды.
-
Көлеңке микроорганизмдердің тез көбеюіне қолайлы. Қараңғы жерде нан мен жеміс жылдам көгеріп, бетінде саңырауқұлақтар мен бактериялар көп пайда болды.
-
Ылғал мен температура да маңызды факторлар болып табылады. Жылы және ылғалды орта микроорганизмдердің өсуін жылдамдатады, ал құрғақ және салқын орта баяулатады.
Бұл тәжірибе оқушыларға микроорганизмдердің тіршілігін бақылауды, теориялық білімді практикамен байланыстыруды үйретеді. Сонымен қатар, тамақты дұрыс сақтау, азық-түліктің сапасын ұзақ сақтау және денсаулықты қорғау жолдарын түсінуге мүмкіндік береді.
Қорытындылай келе, жарық, көлеңке, температура және ылғал микроорганизмдердің өсуіне айқын әсер етеді. Бұл жобаның нәтижесі арқылы біз тамақ сақтау ережелерін дұрыс орындауды үйреніп, микроорганизмдердің тіршілігін бақылауда практикалық дағдыларды дамытуға мүмкіндік алдық.
Пайдаланған әдебиеттер
-
Петрова, Л. «Микроорганизмдер әлемі», Алматы, 2020.
-
Иванова, М. «Табиғаттағы микроорганизмдер», Астана, 2019.
-
Нұрбеков С., “Табиғаттағы тіршілік”, Алматы: Балдырған, 2019. – Жарық пен көлеңкенің тірі ағзаларға әсері.
-
Жартылыстану 4 сынып оқулығы, Алматы: Атамұра
-
Дүйсенбаев Б., “Балаларға арналған тәжірибелер”, Алматы: Білім, 2018. – Қарапайым тәжірибе жасау әдістері.
Ғылыми жобаның күнделігі
Тақырыбы: Жарық пен көлеңкенің
микроорганизмдерге әсері
Орындаған: Шадырова Сауле
Ергешбайкызы
1-күн:
Бүгін мен нан мен жемісті екі бөлікке бөлдім. Бірін күн сәулесі
түсетін жерге, екіншісін қараңғы орынға қойдым. Барлығы таза,
ешқандай өзгеріс байқалмады. Мен алғашқы бақылауды жасап,
фотосуретке түсірдім. Сонымен қатар, әр үлгіні бөлек белгілеп, қай
жерде тұрғанын жазып қойдым.
2-күн:
Көлеңкедегі нан мен жемісте алғашқы аздап көгеру байқалды, бетінде
жеңіл дақтар пайда болды. Жарықтағы үлгілер әлі өзгеріссіз қалды.
Мен күнделікті бақылау жүргізіп, өзгерістерді суретке түсірдім және
журналға жазып отырдым.
3-күн:
Көлеңкедегі үлгілерде көгеру кеңейіп, бетінде саңырауқұлақтар пайда
болды. Жарықтағы үлгілерде тек беткей өзгерістер байқалды. Бұл
микроорганизмдердің көлеңкеге тез бейімделетінін көрсетті. Мен әр
өзгерісті салыстырып жазып, тәжірибені
қадағаладым.
4-күн:
Көлеңкедегі үлгілердің түсі күңгірттеніп, бетінде көгеру айқын
көрінді. Жарықтағы үлгілерде тек жеңіл дақтар пайда болды. Мен
бақылауларымды суретке түсіріп, тәжірибе туралы жазбалар
жасадым.
5-күн:
Көлеңкедегі нан мен жеміс бетінде саңырауқұлақтар көп пайда болып,
иісі өзгере бастады. Жарықтағы үлгілерде тек үстіңгі қабатында
аздап өзгерістер болды. Бұл жарық микроорганизмдердің өсуін
бәсеңдететінін дәлелдеді. Мен әр үлгідегі өзгерістерді салыстырып
жаздым.
6-күн:
Көлеңкедегі үлгілер толық көгеріп, қолмен тигенде жұмсақ, иісі
өзгеше болды. Жарықтағы үлгілерде тек жеңіл беткей өзгерістер
байқалды. Мен әр күнде байқалған өзгерістерді суретке түсіріп,
журналға жазып отырдым.
7-күн:
Тәжірибе соңында көлеңкедегі үлгілер тамаққа жарамсыз болып шықты,
ал жарықтағы үлгілер салыстырмалы түрде жақсы күйде сақталды. Мен
барлық күндердегі өзгерістерді салыстырып, қорытынды жасадым.
Тәжірибе көрсеткендей, жарық микроорганизмдердің өсуін бәсеңдетеді,
ал көлеңке – олардың тез көбейуіне
қолайлы.
8-күн:
Көлеңкедегі үлгілердің бетінде көгеру толығымен таралып,
саңырауқұлақтар бетінің әр бөлігін жабып қалды. Иісі өте күшті және
нәзік қолмен тиіп көруге болмайтын күйде болды. Жарықтағы үлгілерде
тек үстіңгі қабатта жеңіл көгеру байқалды, бірақ иісі әлі қалыпты.
Мен күнделікті бақылауды жазып, фотосуретке түсірдім және
өзгерістерді салыстырдым.
9-күн:
Тәжірибе соңында көлеңкедегі нан мен жеміс толық бұзылғаны
анықталды, оларды адам үшін қолдануға болмайды. Жарықтағы үлгілер
салыстырмалы түрде жақсы күйде сақталды, бетінде тек жеңіл
өзгерістер байқалды, иісі қалыпты. Бұл күн тәжірибенің қорытынды
кезеңі болды: мен барлық күндердегі өзгерістерді салыстырып, жарық
пен көлеңкенің микроорганизмдердің өсуіне әсерін нақты
көрдім.
Аннотация
Бұл ғылыми жобада жарық пен көлеңкенің микроорганизмдердің өсуіне қалай әсер ететіні зерттелді. Жоба барысында мен нан мен көгерген жеміс мысалында микроорганизмдердің тіршілігін бақыладым. Тәжірибе көрсеткендей, жарыққа қойылған үлгілерде микроорганизмдер баяу көбейсе, көлеңкелі және салқын жерлерде олар тез көбейеді. Бұл тәжірибе микроорганизмдердің өсу жылдамдығына жарық пен температураның әсерін нақты көрсетті.
Теориялық бөлімде мен микроорганизмдердің түрлері, олардың қасиеттері, сондай-ақ тамаққа әсері туралы қарапайым және түсінікті ақпарат бердім. Практикалық бөлімде мен күнделікті бақылау жүргізіп, өзгерістерді суретке түсіріп, күнделікті жазбаларға тіркедім. Сонымен қатар, мен тәжірибе нәтижелерін салыстырып, қорытынды жасадым.
Бұл жоба оқушыларға микроорганизмдердің тіршілігін көрнекі түрде бақылауға, тәжірибелік дағдыларды дамытуға және тамақты дұрыс сақтау жолдарын үйренуге мүмкіндік береді. Жоба сонымен қатар логикалық ойлау қабілетін, салыстыру және қорытынды жасау дағдыларын жетілдіреді. Жобаның нәтижелері мектептік ғылыми жобалар конкурсына ұсынылуға және оқушылардың ғылымға деген қызығушылығын арттыруға лайық.
Аннотация
В этом научном проекте изучалось, как свет и тень влияют на рост микроорганизмов. В ходе исследования я наблюдал жизнь микроорганизмов на примере хлеба и заплесневелых фруктов. Эксперимент показал, что микроорганизмы растут медленно на свету, а в тени и в прохладных местах они размножаются быстрее. Это наглядно продемонстрировало влияние света и температуры на рост микроорганизмов.
В теоретической части проекта я представил информацию о видах микроорганизмов, их свойствах и влиянии на продукты питания. В практической части я ежедневно проводил наблюдения, фиксировал изменения с помощью фотографий и записей в дневнике. Также я сравнивал результаты эксперимента и делал выводы.
Проект позволяет учащимся наглядно наблюдать жизнь микроорганизмов, развивать практические навыки и учиться правильно хранить продукты. Он способствует развитию логического мышления, навыков сравнения и умения делать выводы. Результаты проекта подходят для участия в школьных научных конкурсах и повышают интерес детей к науке.
Abstract
This scientific project studies how light and shade affect the growth of microorganisms. During the research, I observed the life of microorganisms using bread and moldy fruit as examples. The experiment showed that microorganisms grow slowly in the light, while in shaded and cool places they multiply faster. This clearly demonstrated the effect of light and temperature on microorganism growth.
In the theoretical part of the project, I provided information about the types of microorganisms, their properties, and their effects on food. In the practical part, I conducted daily observations, recorded changes with photos, and kept a daily journal. I also compared the results of the experiment and made conclusions.
The project allows students to visually observe the life of microorganisms, develop practical skills, and learn how to store food properly. It helps to develop logical thinking, comparison skills, and the ability to make conclusions. The results of the project are suitable for school science competitions and help increase students’ interest in science.
шағым қалдыра аласыз














